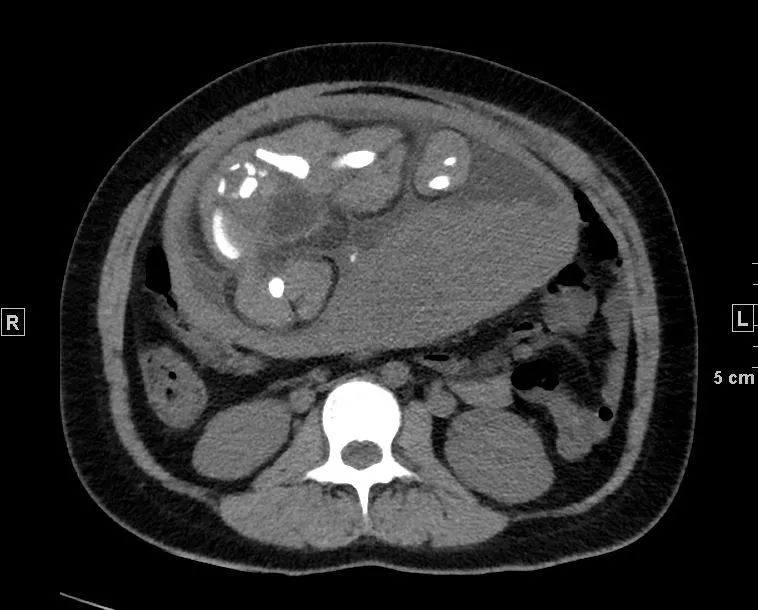
心冠动脉夹层能治愈吗,夹层动脉血管破裂症状
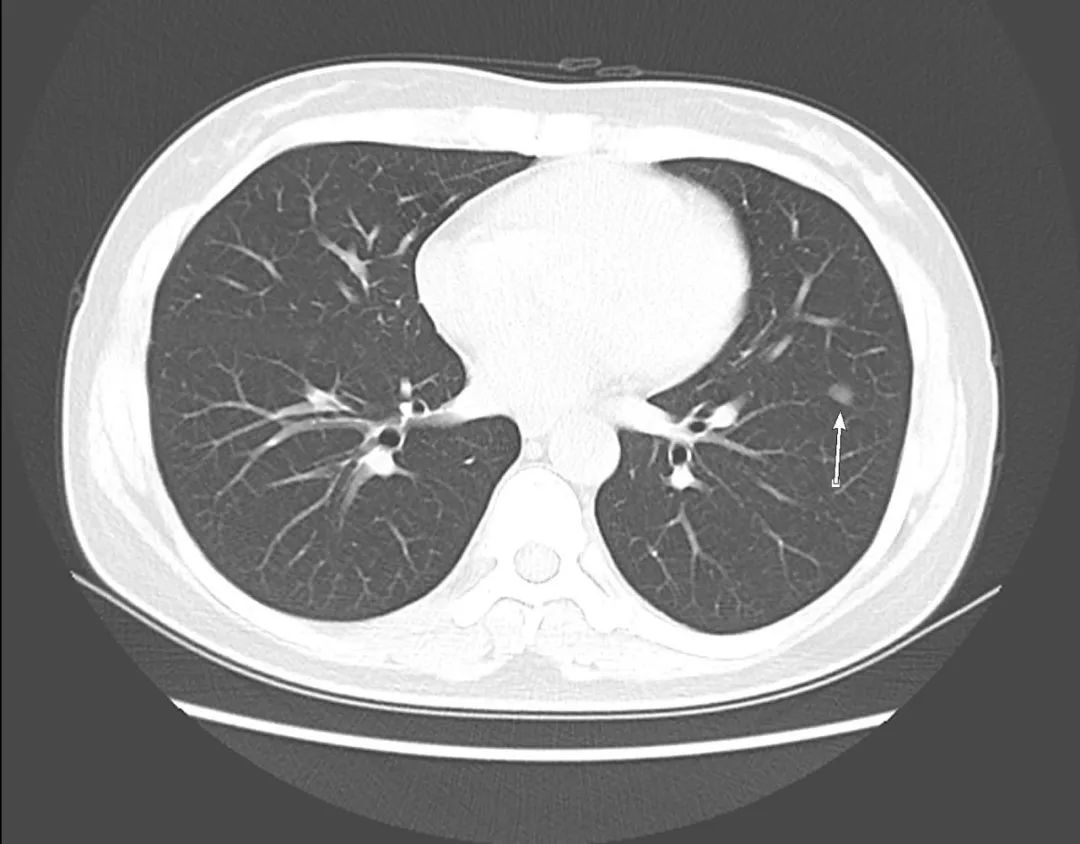
心冠动脉夹层能治愈吗,夹层动脉血管破裂症状

不想错过界哥的推送?
戳上方蓝字“医学界心血管频道”关注我们
并点击右上角“···”菜单,选择“设为星标”

多一份认真细致,便给患者多一份安心。
文丨杜华阳
来源丨医学界
作为一名影像科大夫,会遇到很多病人,黑白图像背后隐藏着太多故事,这些故事或危急、或让人啼笑皆非、或使人宽慰……影像科的故事,没有你见不到,只有你想不到。下面讲一下给在影像科给我印象最深的三个故事。
不一样的钙化竟是动脉夹层
不一样的钙化竟是动脉夹层
“大夫,我爸腰疼!疼的实在受不了,就过来了!”
“疼了大概有多久了?”
“具体我也说不清楚,有20来天了。老人说是之前搬一袋大米,就是一不小心扭到腰了。几年前,骨科大夫就说是腰椎间盘突出,一直没治,现在应该是加重了。”
“患者疼痛时是一阵一阵的疼,还是一直疼,还是运动的时候疼?”
“应该是一动就疼,有的时候是一阵一阵的疼……这个我不是很清楚。”
“患者本人在哪?我想看一下患者本人。”
这是去年接近年关的下午,一位72岁男性患者因腰痛来就诊,急诊大夫开了腰椎间盘CT检查。腰椎间盘CT平扫是CT检查中比较好写的,即使对于初年资的影像诊断医师,十来分钟写一份是丝毫没有问题的,更何况对于我们中级的值班大夫。
患者的腰椎间盘突出不是严重,之所以将患者家属喊来询问病史,是因为看到了腹主动脉血管壁钙化,确切的说是“不一样”血管壁钙化,腹主动脉(双肾下极水平以下)内分隔影伴钙化(如下图):

正常情况下,老年人血管壁有钙化是再正常不过,但钙化即使再严重,也是呈环形贴着血管壁,上面这样钙化很怪异,分隔伴细条状钙化。如果没有任何症状,可能是正常的;但当有症状时,而且腰痛用正常的腰椎间盘突出难以解释时,不能除外一种相对少见但非常危险的情况——“主动脉夹层”。
当在急诊CT外,看到患者本人时,正在座椅边旁蹲着,后背使劲靠在座椅角上,右手按着后背、咬着牙,额头上稍微有些湿。
“一直疼吗?具体哪一块疼?”
“对,一直…疼…疼,这一片都很疼”,说着指着后背,几乎是双侧髂嵴以上、肋骨以下。“我吃了两片布洛芬,还是……特别疼。”
这个患者的L3-5椎间盘轻度膨出,双侧侧隐窝稍变窄。正常情况,腰椎间盘膨出压迫硬脊膜囊,即使压迫双侧神经根,通常会使双下肢疼痛、活动受限,使患者如此疼痛的,很少见。最后,报告“夹层不除外,建议患者行增强CTA”。
还好,那一下午人不不多,很快开申请单、登记、预约,一小时后做了胸腹盆增强CTA,当看到增强图像时,让我们倒吸一口凉气,约L1椎体水平至左侧髂总动脉夹层。患者紧急住院。

腹主动脉CTA腹腔干水平(骨窗) 左侧髂总动脉(骨窗)
该案例被当成教学的典型案例,之前就有过漏诊夹层而致患者死亡的惨痛代价,当回顾影像学时,还能看出一些端倪。“看见异常,千万不要漏诊”,这是给指导老师我印象最深的一课。
大夫,我的孩子还能要吗?
进入小年后的上午,正常写CT报告,35岁的女性,胸部高分辨CT平扫(含上腹),急诊申请单上写着“低氧血症”。胸部CT显示双肺多发实变影、斑片影,典型的肺部感染;当我看到上腹时,心猛然一震——“妊娠子宫”,已达脐上,孕至少20周以上。
旁边的小超不知何时来了一句“腹腔可见妊娠子宫,这很好写。孩子估计留不下了!”
下午登记台给我打电话,有病人找。出去时心里忐忑不安,“千万别是报告有问题,想过个安生年”。当出去时,中年男性拿着报告单,“报告单上写着你的名字”,我又紧张一些,真害怕是报告问题。“我这里不认识别人,就想咨询您一些问题。”我瞬间安下心来。
“大夫,我的孩子还能要吗?”我看报告单,正是我写的低氧血症的女性。“我们看了好多医生,吃了好多药,喝了好多中药才怀上的。”他说着,几近哭泣。
“在登记时,都能清楚的看到提醒标识:‘孕妇及准备怀孕女性检查前请告知CT检查医师’,如果怀孕了,我们不建议做CT检查。”
“咱们这有没有怀孕做了CT检查,没有问题的?曾经有过这样的例子吗?”
心里马上怂了,与其说怂了,倒不如说不敢说出任何让他抱有希望的话,不知道他们经历了什么,也深知他最想要的答复是“是,孩子可以留下,我见过类似的例子”,谁敢给他这样的承诺?我也只能推诿,“这个问题,你最好问一下妇产科大夫,他们考虑的会多一些。”
他一直忏悔“早知道这么严重,就早点来看了;媳妇怀孕了,不敢轻易吃药,害怕对孩子不好;哪知道会那么严重……”
我忘记了怎么安慰的他,反正给他说了很多话,类似“好好治疗,一定母子平安”,心里却是异常沉重。
虚惊一场的磨玻璃结节
肺内结节总是让非学医者担惊受怕,寝食难安;肺内磨玻璃结节,更是让人闻风丧胆,即使学医者,也还是乖乖密切随诊复查。在年前最后一次巡诊班,我接待过让患者虚惊一场的“磨玻璃结节”。(PS:巡诊,顾名思义,处理正常时间该出但因各种原因未出的报告,当然也会接待一些对报告有疑问、需要解释的患者)。
接近年关时,病人寥寥无几。突然进来一名青年女性,一脸焦虑与愁容,“大夫,您给我看一下我妈的CT,是不是癌症,是不是已经晚期了?”
“我在XX医院检查,写的是“左肺结节”,在咱们医院检查报的是“左肺磨玻璃结节”,我在网上查的是“磨玻璃结节是肺腺癌”,说着把手机拿向我让我看。我瞬间听出了症结所在。
在报告单上查迅速查到患者ID,是胸部CT平扫(含上腹)检查,打开了图像,大致浏览了全层图像,找到了报告标注的左肺结节。一眼看上去,觉得是一个光滑结节,不像是腺癌一样恶性磨玻璃结节。患者只做了肺部CT平扫,肺窗只有5mm,只能在两个层面观察到结节,提供的信息很少。
虽然已有很大把握,很大程度上这不是恶性结节征象,依然担心因CT检查时各种参数设置、不同的算法影响观察,医学很难说有100%,医学领域一切皆有可能。
“你还在其他医院做过检查是吧?老片带了吗?可以前后对比一下老片。”
她迅速拿出了外院的胶片,五天前检查的。在5×7的小格上面,我费力地找到了一个“实性小实点儿”,也就是这次显示的“磨玻璃结节”。两次的检查,更加确定我心里想法。
“不同的人写报告,有一定差别,磨玻璃结节、磨玻璃影不一定都是恶性。我看着这不像恶性的,临床上考虑的会更多,可能还会进行肿瘤标记物的检查。要是肿瘤标记物在正常值以内,就不用担心;有时稍微高出正常值,因为特异性和灵敏度不同,只要不是成倍的高、一般问题不是很大。”
等等,我看到了最后面0.625mm序列的纵隔窗,我调成肺窗,和5mm厚层对准,终于找到了所谓磨玻璃结节的层面,原来是左肺叶间裂胸膜结节样增厚,在厚层上呈现结节。
这不是第一次将胸膜当成肺内结节,如果稍加注意,调一下窗宽窗位,可能就能避免使患者一家人惶惶不可终日,让他们多一些心安。

纵隔窗调成肺窗,显示左肺叶间裂结节样增厚
影像科每天都会上演形形色色的故事,这些故事在学医的我们眼里或许很简单,却是他们对健康的关注、对疾病的担忧的真实反映。
你永远不知道他们为此事经历了什么。当你或多或少知道他们的事情,总给我们以感动,给我们以力量,在工作的道路上更加严谨、认真、一丝不苟。
你经历过患者的哪些故事? 不妨给我们留个言吧。
觉得好看,请点这里
↓↓↓↓